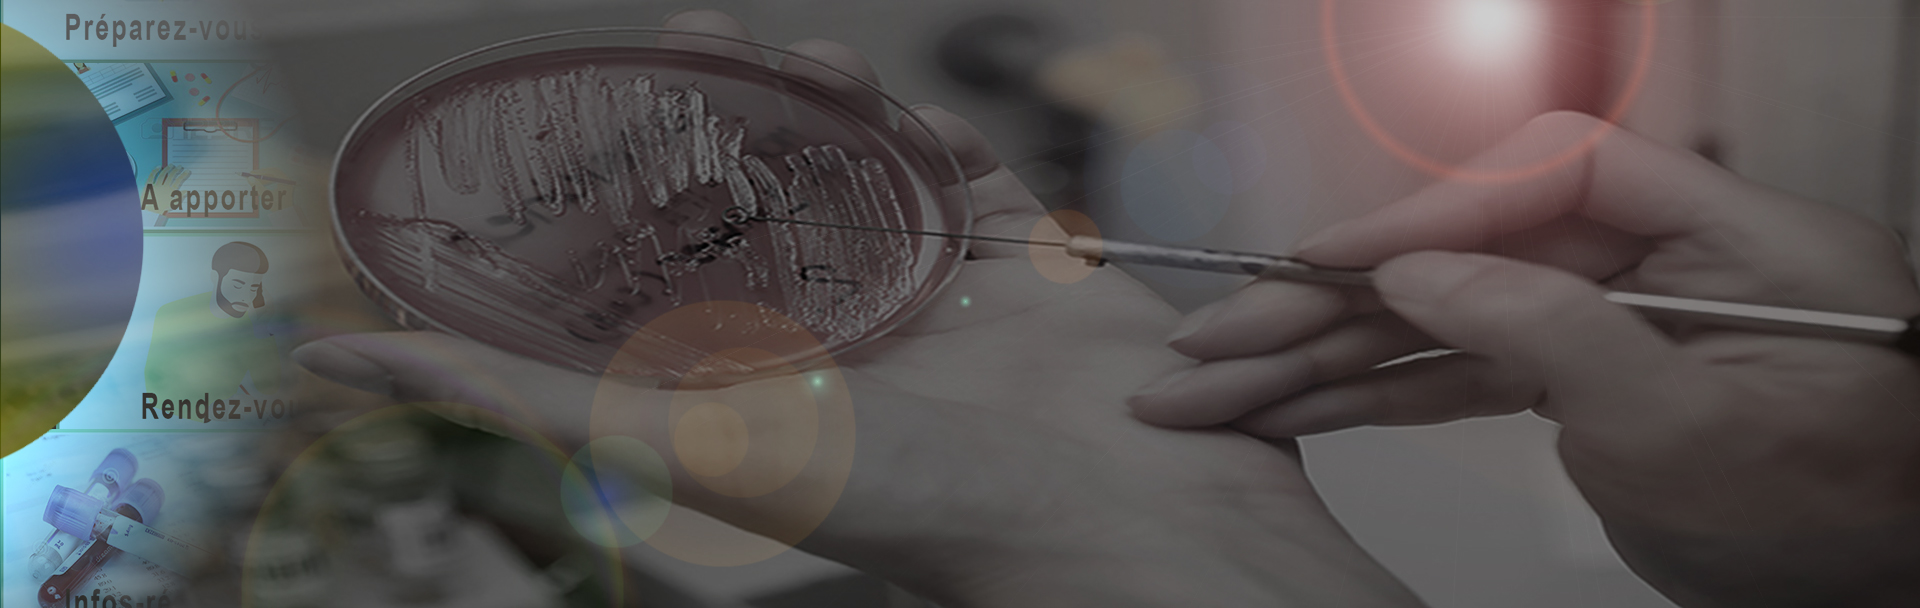
Second slide

quelques recommandations avant de venir à notre laboratoire d'analyse
¨ SE PREPARER







Pour certains examens, il est nécessaire d'être à jeun, pour d'autres des préconisations s'imposent...
Tests nécessitant d'être à jeûn :
Acide lactique (lactates) - CTX (Crosslaps) - Cholesterol - Bilan Lipidique - Gastrine, Glycémie - HGPO (Hyperglycémie provoquée) – Homocystéine - Test d'O'Sullivan – Test HELIKIT * - Testostérone biodisponible
Détail des préconisations par examen.
(les examens absents de la liste ci-jointe sont sans contraintes de préparation).. « Voir la liste »
Fiche de préconisations :
Bilharziose
Recueil d'urines sur 3 heures
BK dans les urines
Recueil d'urines sur 24 heures
Recueil des urines sur échantillon
Recherche de sang dans les selle
Coproculture/Parasitologie des selles
Scotch test
Examen Cyto Bacterio-Urinaire
Spermoculture
Expectoration
Recueil d'urines 1er Jet
Frottis urinaire
Que signifie "être à jeun" pour vos analyses ?
Nous considérons le jeûne comme une période de 10 à 12 heures après votre dernier repas.
Jeûne non strict
Vous pouvez boire un verre d’eau et vous brosser les dents (à la différence du jeûn strict qui précède une anesthésie générale).
Jeûne strict
précède une anesthésie générale
* Vous ne pouvez ni boire un verre d’eau, ni vous brosser les dents, ni fumer.
¨ A APPORTER







Certains documents sont nécessaires pour permettre la prise en charge
Pour un meilleur enregistrement de votre dossier et la prise en charge de vos frais, merci d’apporter les documents suivants :

Votre Carte Chifa à jour ou une attestation de sécurité sociale en cours de validité.

Votre Carte Mutuelle couvrant les analyses.

Votre L'Ordonnance
Les analyses sans ordonnance sont possibles avec une fiche de consentement mais facturées directement.

Pour une question d'indentito-vigilance, il peut vous être demandé un document justifiant de votre Identité.

Tout autre document spécifique aux analyses :
• consentement éclairé pour les analyses génétiques
• le compte rendu d’échographie pour la dépistage de la Trisomie 21 chez les femmes enceintes...
ATTENTION : L'absence d'un document peut amener le laboratoire à devoir facturer ses actes directement sur place, au moment de l'enregistrement.
¨ RENDEZ-VOUS







Venir au laboratoire ne nécessite pas de rendez-vous
Les prises de sang et recueils urinaires ont lieu sans rendez-vous et sans interruption.
Pour les prises de sang à domicile, nous vous remercions de contacter le site le plus proche du lieu de prélèvement souhaité.
Néanmoins, pour les examens suivants, veuillez vous renseigner auprès du laboratoire :
• prise de sang
• prélèvements vaginaux et urétraux
• test de Hühner, frottis, spermogramme
• peau, muqueuses, ongles, cuir chevelu...
• sphère ORL (gorge, nez, oreille,...)
• prélèvement mycologique
• recherche de gale
• scotch test
• test synacthene
¨ INFOS RESULTATS






Les résultats de vos analyses sont rendus le jour même à partir de 18h, à l'exception de certaines analyses spécialisées ou de bactériologies demandant un temps de traitement plus important.
Nous communiquons vos résultats à votre médecin selon votre demande et tenons à votre disposition le compte rendu au laboratoire pour récupération et interprétation si nécessaire. En cas de résultats fortement pertubés, ceux-ci seront communiqués en urgence à votre médecin par téléphone ou fax.
Sur demande, les résultats sont envoyés par courrier à votre domicile (sauf certains résultats du type analyses génétiques, HIV, en conformité par rapport à la Loi ou par souci de confidentialité en cas de problème d'acheminement du courrier) et au cabinet de votre médecin
Dans un souci d'amélioration continue du service et de la qualité, nous mettrons en place un système de mise en ligne de vos résultats sur internet. Cela se fait à travers un accès sécurisé et le téléchargement d'un fichier...
Pour vos résultats par internet, nous vous informons que les essais de connexion sont limités à 10. L'impossibilité de se connecter peut provenir de la non soumission de vos résultats à notre serveur, ces derniers pouvant ne pas être totalement réalisés au moment de la connexion. Il est donc recommandé de ne pas insister si votre connexion ne fonctionne pas afin d'éviter le blocage du compte. Néanmoins, si votre compte s'inscrit comme bloqué, veuillez contacter votre laboratoire pour qu'il le réactive.
¨ EN SAVOIR PLUS
• Votre ordonnance.
• Votre carte CHIFA à jour.
• Votre attestation de mutuelle (vérifiez que votre mutuelle prend bien en charge les analyses).
• Votre attestation de sécurité sociale (CNAS).
Cela dépend de votre couverture sociale et de la prescription. Nous sommes à votre disposition pour vous expliquer les raisons d’une facturation.
Il est important de mettre à jour régulièrement votre carte vitale.
Les résultats de la plupart des analyses sont disponibles le jour-même. Quelques examens, notamment ceux de bactériologie, nécessitent un délai plus long.
N´hésitez pas à vous renseigner auprès de notre secrétariat.
Les compte-rendus d´analyses peuvent :
• être remis personnellement à l´accueil du laboratoire à partir de 18h.
• vous être envoyés par poste.
Conformément à la législation, seul fait foi le compte-rendu sur papier avec en-tête du laboratoire et signature du biologiste.
Par souci de confidentialité, les résultats ne peuvent pas être communiqués au patient par fax ou mail.
Vos résultats d´analyses seront transmis au médecin prescripteur à votre demande.
Ces résultats pourront aussi être communiqués en urgence à votre médecin par téléphone, fax ou messagerie sécurisée, dans les circonstances suivantes :
• à l´initiative du laboratoire, en cas de résultat pathologique nécessitant une intervention urgente du praticien.
• à la demande du prescripteur.
Les résultats sont disponibles par internet dans notre laboratoire. Pour ce faire, il vous suffit d'en faire la demande lors de l'enregistrement de votre dossier à l'accueil du laboratoire. Un identifiant et un mot de passe vous seront remis.
C´est votre médecin qui pourra faire la meilleure interprétation de vos résultats d´analyses puisqu´il détient toutes les informations cliniques ayant motivé cette demande.
Il connaît votre dossier médical et saura quels sont, éventuellement, les examens complémentaires à demander.
À votre demande le biologiste pourra vous donner une première interprétation de vos résultats.
Enfin, nous vous rappelons que les normales ou valeurs usuelles présentes sur votre compte-rendu d´analyses ont été établies en fonction de votre sexe et de votre âge.
Le biologiste contactera votre médecin. Il pourra aussi vous contacter directement.
Information aux femmes enceintes:
Le suivi médical lors de la grossesse est important. Plusieurs examens d’analyses biologiques sont obligatoires, certains vous mobilisent plusieurs heures.
Recherche de drogues urinaires:
Il s’agit d’un recueil urinaire réalisé directement au laboratoire. Une pièce d’identité peut vous être demandée sur place.
Pour ne pas interférer ou rendre l’analyse impossible par la circulation de particules de lipides présentes dans le sang. Cet état de jeûne est un des éléments permettant la bonne exécution technique de vos analyses et une interprétation pertinente de vos résultats. Vous pouvez boire un verre d’eau et vous brosser les dents (à la différence du jeûne strict qui précède une anesthésie générale). Toutes les analyses ne nécessitent pas le jeûne, renseignez-vous auprès du laboratoire.
Le résultat peut varier selon l’heure de la journée à cause de l’horloge biologique. Le plus souvent, il est préférable d´être à jeun et, par conséquent, vous devrez vous présenter au laboratoire avant de prendre votre petit-déjeuner, 10-12 heures après votre dernier repas.
Certains éléments du sang ont un taux qui varie au cours de la journée; on parle de rythme circadien; c´est le cas du cortisol, par exemple. En réalisant habituellement les dosages sur un échantillon de sang prélevé le matin, on standardise le prélèvement et on facilite l´interprétation des résultats, les valeurs normales des analyses ayant été définies à jeun et au lever.
Sauf dosage d´un médicament devant être pratiqué après la prise à la demande de votre médecin (par exemple ciclosporine 2 heures après la prise), il est recommandé de ne pas prendre de médicaments avant une prise de sang. D´une part parce que cela peut avoir un impact sur les analyses (interférence ou effet direct sur le paramètre dosé); d´autre part parce qu´il est généralement déconseillé d´absorber des médicaments à jeun et de le rester pendant une heure minimum après ingestion (passage accéléré dans le sang, risque de nausées, intolérance digestive,...).
>> En cas d’appréhension avant la prise de sang :
Votre médecin traitant peut vous prescrire une crème ou des patchs anesthésiants, remboursés par la sécurité sociale. Ces produits sont souvent utilisés pour les enfants afin d'éviter qu’ils ne ressentent la moindre douleur.>> Pendant le prélèvement, l’aiguille, ça pique un peu !
Lors du passage de l’aiguille dans la peau, des petits filets nerveux transmettent la sensation de douleur au cerveau. Le matériel utilisé par le laboratoire est étudié pour minimiser ce désagrément, la plupart du temps on ne sent presque rien. Si vous appréhendez la prise de sang, n’hésitez pas à en parler au préleveur. Faites lui confiance, il est expérimenté.
>> Après le prélèvement, j’ai parfois un bleu !
Après la prise de sang, si la veine ne se referme pas assez vite, le sang coule entre la peau et la veine. Ce n’est pas systématique et cela dépend de la physiologie de chacun.
>> Pour éviter d’avoir un bleu :
Appuyer sur le coton pendant 2 mn.
Ne pas faire d’effort important dans la ½ h suivant le prélèvement.
Garder le pansement au moins 1 h.
Un seul tube nécessaire pour une analyse => C'est une fausse idée reçue. Le nombre de tubes prélevés dépend de la technique utilisée
Les tubes contiennent des produits chimiques utiles à l’analyse. Pour les reconnaître, des codes couleurs ont été définis dans une norme européenne. Ex : les tubes avec les bouchons bleus servent à étudier la coagulation du sang.
Les déchets d’activités de soins suivent un circuit d’élimination très réglementé. Le sang au final est incinéré.
Le prélèvement vaginal consiste en la recherche d´une infection au niveau vaginal (et de l´endocol, éventuellement). Le frottis cervico-vaginal est un examen anatomopathologique visant à dépister le cancer du col de l´utérus. Le prélèvement peut être réalisé par un médecin (gynécologue, anatomopathologiste ...) ou médecin biologiste.
Nos flacons sont stérilisés, ils ne contiennent pas de substance pouvant gêner l’analyse (détergent, sucre, contamination par des bactéries).
Oui, il est indispensable de préciser sur le flacon:
• Votre nom
• Votre prénom
• Votre date de naissance
D’autres renseignements tels que la date, l’heure du recueil, le traitement antibiotique en cours, la conservation de l’échantillon sont utiles.
L’ « Examen Cyto-Bactériologique des Urines » est préconisé dans le cadre d’une recherche d’infection urinaire et permet de déterminer le germe en cause en vue d’appliquer une antibiothérapie adaptée, si nécessaire. Cet examen doit se faire avant tout traitement antibiotique ou 3 à 4 jours après arrêt du traitement
Cf Fiche de préconisation : Cliquez ici.
Le Compte d´ADDIS ou HLM (Hématies-Leucocytes par Minute) est une analyse qui consiste à mesurer le débit des hématies et des leucocytes passant dans les urines. Ce recueil s’effectue sur la totalité des urines émises en 3 heures.
Cf Fiche de préconisation : Cliquez ici.
Cf Fiche de préconisation : Cliquez ici.
Si vous pouvez vous déplacer, amenez votre bébé au laboratoire et nous réaliserons le recueil.
Sinon, suivez les recommandations ci-dessous :
Surtout, ne pas essayer d´extraire les urines de la couche!
Nettoyez bien le méat urinaire et la zone située autour avec les produits antiseptiques que vous utilisez habituellement.
• Posez une petite poche type urinocol, que le laboratoire peut vous fournir, selon les instructions du fabricant.
• Ne la laissez pas en place plus d´une heure. Si le bébé n´a pas uriné, il faut coller une autre poche.
• Une fois les urines émises, obturez la poche en repliant sur eux-mêmes les bords de l´ouverture, et apportez cette poche dès que possible au laboratoire.
• Déposez la poche dans un flacon stérile et apportez-le au laboratoire rapidement.
Cf Fiche de préconisation : Cliquez ici."
Coproculture et examen parasitologique des selles. Cet examen a pour objet de reconnaître les diarrhées d’origine infectieuse, de déterminer l’agent en cause en vue d’appliquer une antibiothérapie adaptée, si nécessaire.
Cf Fiche de préconisation : Cliquez ici.
Un(e) biologiste est obligatoirement médecin ou pharmacien, il s'agit d´une discipline médicale.
Il (elle) passe un concours à la fin de son cursus universitaire général et choisit la biologie médicale comme spécialité.
Au terme de quatre années d´internat dans un centre hospitalier universitaire, au cours desquelles il (elle) valide sa formation dans les différentes disciplines de la spécialité (hématologie, bactériologie, immunologie, chimie, parasitologie...), il (elle) devient titulaire d´un D.E.S. de biologie médicale qui lui permet de devenir directeur (trice) d´un laboratoire de biologie médicale, soit après dix années, au minimum, d´études supérieures.
Notre profession est réglementée. Plusieurs organismes de tutelle sont chargés du contrôle de nos activités :
• Agence Régionale de Santé
• Assurance maladie
• Ordre des Pharmaciens
• Ordre des Médecins
...
Par ailleurs, tous les laboratoires de biologie médicale doivent être accrédités par le:
1/ OEC (Organismes d’Evaluation de la Conformité)... Normes ISO 15189
2/ Par le Ministére de la santé: Cliquez ici.
Notre laboratoire a largement entamé cette démarche avec la mise en place d'un système-qualité et d'accréditation OEC sur une portée de son activité.
Sont concernées les 3 phases de notre activité: le pré-analytique, l´analytique et le post-analytique.
• Le pré-analytique, c´est tout ce qui précède l´analyse en elle-même, du prélèvement jusqu´à la mise en place du tube sur l'automate, y compris le transport des boîtes de prélèvement.
• L´analytique concerne l´analyse proprement dite de votre prélèvement : méthodes d´analyses, appareillages utilisés, étalonnages, contrôles, validation technique des résultats,...
• Le post-analytique comprend la validation des résultats par le biologiste, le rendu des résultats,
• la formation du personnel, la maintenance des appareils,...
Copyright © 2017 Laboratoire d'Analyses Médicales d'Oran - Clinique Dr Ali Boukhatmi